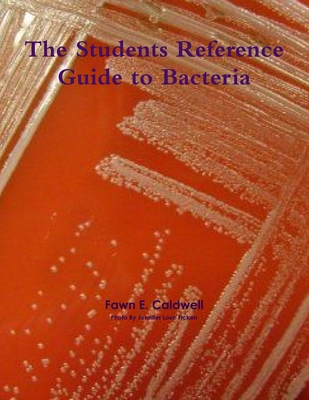
The Students Reference Guide to Bacteria 1257424165 Book Cover

With this book the student will be able to find the name of the bacteria, some of the tests used to identify it and other valuable information. Furthermore, there will be some information on what diseases or benefits the bacteria may have. The student will further will be able...